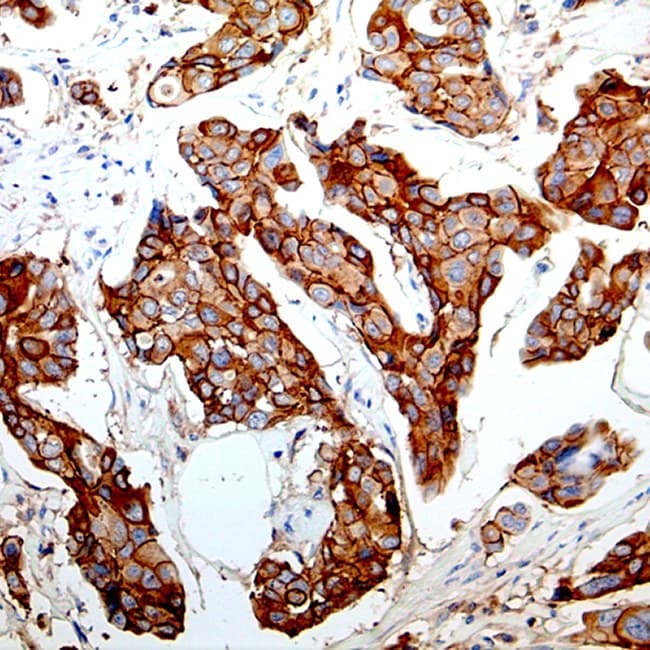

L’E-cadhérine (codée par CDH1) est une protéine d’adhérence cellulaire transmembranaire qui joue un rôle central dans l’intégrité épithéliale.
En pathologie chirurgicale diagnostique, la détection immunohistochimique (IHC) de l’E-cadhérine est un biomarqueur établi utilisé pour :
- identifier de manière différentielle le carcinome lobulaire invasif (ILC) par rapport au carcinome canalaire invasif (IDC) du sein, étant donné que la perte de coloration membranaire de l’E-cadhérine est une caractéristique de nombreuses lésions lobulaires.
- fournir des informations pronostiques ou phénotypiques dans certaines tumeurs gynécologiques (carcinomes de l’endomètre et de l’ovaire) où une expression réduite de l’E-cadhérine est corrélée à un grade plus élevé, à l’invasivité ou à une biologie tumorale distincte.
Principaux avantages et applications cliniques
- Diagnostic différentiel des lésions mammaires lobulaires et canalaires : coloration membranaire claire dans les phénotypes canalaires et coloration membranaire absente/atténuée dans les phénotypes lobulaires classiques ; souvent utilisé conjointement avec les panels p120/β-caténine pour une interprétation concordante.
- Outil complémentaire dans les panels gynécologiques : aide à l’évaluation du grade/de l’invasion dans le carcinome de l’endomètre et peut contribuer à la classification des sous-types dans les tumeurs épithéliales ovariennes.
- Validé pour les tissus FFPE et les plateformes automatisées : de nombreux clones CE/IVD (EP6, HECD-1 et autres) sont optimisés pour les spécimens fixés au formol et inclus en paraffine et pour les colorateurs automatisés utilisés dans les laboratoires cliniques.
- Harmonisation et sélection des clones : des travaux multicentriques récents mettent en évidence la variabilité inter-clones et recommandent des critères d’interprétation harmonisés et la sélection de clones validés afin de réduire les discordances dans les cas difficiles.
Ces utilités cliniques rendent les réactifs anti-E-cadhérine robustes et marqués CE (CE/IVD) essentiels pour les laboratoires de pathologie qui ont besoin d’outils IVD validés et conformes à la réglementation pour les diagnostics de routine et les panels cliniquement exploitables.